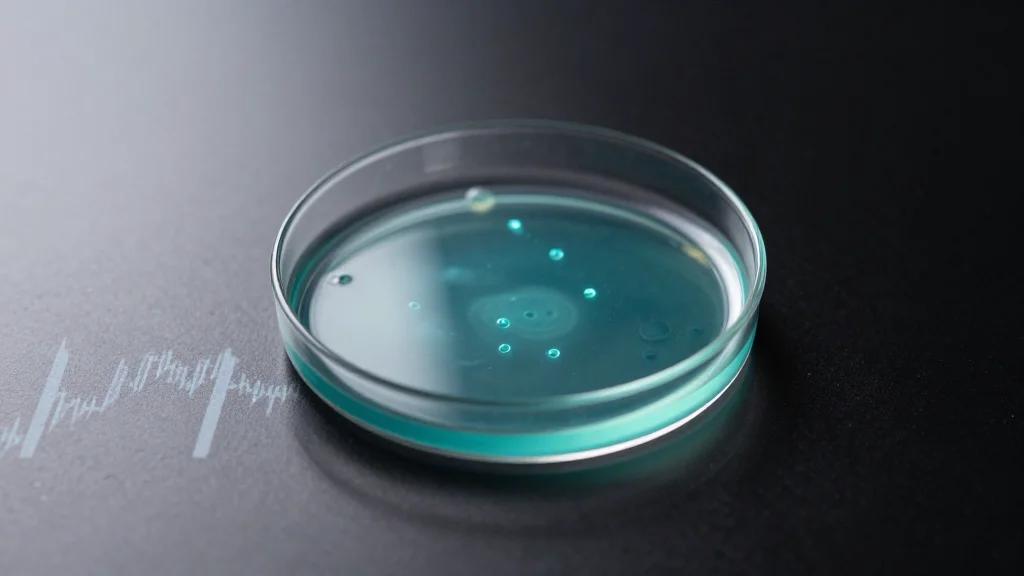
HCW Biologics Appeals Nasdaq Notice, Targets Phase 1 Data for HCW9302 in H1 2026

Hachette Pulls Mia Ballard’s ‘Shy Girl’ Over Suspected AI‑Generated Text
Hachette announced it will not publish Mia Ballard’s horror novel ‘Shy Girl’ in the United States and will pulp the U.K. copies after AI‑detection software flagged extensive passages as likely generated by artificial intelligence. The move marks the first known instance of a major publisher withdrawing a title over AI‑authorship concerns, sparking a heated debate about editorial standards and author accountability.

Disney’s $1 B Sora Deal Collapses as OpenAI Shuts Down Video AI
Disney and OpenAI announced a $1 billion partnership in December to let users generate videos featuring Disney icons via OpenAI’s Sora text‑to‑video tool. On March 24, OpenAI abruptly shut Sora, leaving the deal unfulfilled and igniting criticism from creators and the Writers...

AI Can Mislead on Taxes; User Remains Accountable
Using AI for complex decisions can create a false sense of confidence. In areas like taxes, where details and edge cases matter, AI can simplify explanations but still miss important nuances or context. What feels like clarity can lead to costly...

Roscosmos Confirms Post‑ISS Station Built From New ISS Modules
Speaking at the Federation Council, Roskosmos chief also confirmed that the post-ISS station would be assembled at ISS out of (New) Node, Science & Power and Airlock modules (as I illustrated back in 2021 ;) Context: https://t.co/wVxTkUEbNa https://t.co/zOHPUfG7hC

NASAWatch on TV
NASAWatch founder Keith Cowing is appearing on several major television networks today, including CNN International, the BBC, and Deutsche Welle, to discuss NASA’s Artemis III mission and related space initiatives. The segments feature live launch coverage and expert analysis, with additional interviews...

Maximize Existing Grid to Accelerate Energy Transition
Using more of the grid we’ve already built #energysky -- via Volts/David Roberts: https://t.co/f0TdRT19Bj https://t.co/nR8WVvUHdJ

StepFun 3.5 Flash Is #1 Cost-Effective Model for OpenClaw Tasks (300 Battles)
StepFun 3.5 Flash emerged as the top‑ranked model on the OpenClaw gaming benchmark, achieving a score of 1,327 ± 88 over 98 battles. It outperformed Grok 4.1 Fast (1,274 ± 70) and Minimax M2.7 (1,182 ± 75), securing the most cost‑effective position among 15 contenders. The ranking is provisional,...

How Successful Space Businesses Identify Risk and Strengthen Resilience
Successful space firms now treat risk as a test of corporate survival, prioritizing cash generation, customer concentration, and balance‑sheet discipline over pure launch‑failure scenarios. Rocket Lab posted record $602 million revenue and a $1.85 billion backlog for 2025, while Planet reported $307.7 million...

Macy's AI Chatbot Spurs 400% Sales Jump, Boosting Turnaround
Macy's has rolled out "Ask Macy's," a Google Gemini‑powered shopping assistant, and shoppers who use the bot spend roughly 4.75 times more than non‑users, delivering a 400% lift in sales during the test phase. The surge bolsters the department‑store chain’s...

Activist Irenic Capital Takes 2.5% Stake in Snap, Calls for Board, Cost and AI Overhaul
Irenic Capital Management disclosed a 2.5% holding in Snap Inc., demanding a board revamp, workforce reductions and a shift to AI‑driven ad monetization. The activist push sent Snap shares up more than 13% in a single session, reviving debate over...

More than 16 Lakh Government Email Accounts Migrated to Zoho’s Cloud Platform at a Cost of ₹180 Crore
The Indian central government has shifted 1.66 million official email accounts to Zoho’s cloud platform, incurring a total outlay of roughly $22 million. Monthly pricing ranges from $2 to $4 per account, depending on mailbox size. The move is framed as a...

Anthropic Rushes to Limit Leak of Claude Code Source Code
Anthropic PBC moved quickly to contain an accidental public release of the source code powering Claude Code, its flagship AI‑assistant that drives most of the company’s revenue. The firm issued copyright takedown notices that removed thousands of copies from GitHub....

Tata Communications Unveils IZO™ Self‑Healing Network for AI‑Driven Enterprises
Tata Communications launched IZO™ Data Centre Dynamic Connectivity, a software‑defined, self‑healing network that spans five continents and targets AI‑driven workloads. The platform promises >99.99% service availability and up to 30% operational cost reductions through deterministic multi‑path routing and consumption‑based pricing.

AI's Hidden Costs: Debt Accumulation and Coding Pitfalls
I like AI and use it, but we can also do worse work and terrible things with it. Two articles I read today: What kinds of new debt are teams accumulating with AI? https://t.co/9SRgF4KdgU Some uncomfortable truths about AI coding agents https://t.co/pfPI2yTMEO

Quantum Optimisation Cuts Measurement Needs with New Bayesian Approach
Researchers Siran Zhang and Shuming Cheng at Tongji University introduced a resource‑efficient Quantum Approximate Optimisation Algorithm (QAOA) that targets the cut value of the most probable bitstring and incorporates Bayesian optimisation with adaptive shot allocation. Tested on 3‑regular MaxCut instances,...

AI Adoption Is Real, but so Is the Change Required - Lessons From an ASUG Talks Podcast with SAP CEO...
SAP CEO Christian Klein told an ASUG Talks podcast that AI is no longer a peripheral technology but a force multiplier demanding wholesale business redesign. Companies are underestimating the scale of change, especially the need for process redesign and data...

Neuron Factory Lands Strategic Investment Round to Scale AI-Native Construction Platform
Neuron Factory announced a strategic investment round backed by Zacua Ventures, Trimble Inc., Suffolk Technologies, Imad Ventures and existing backer Colle Capital. The funding will accelerate the rollout of its AI-native knowledge‑graph platform that aims to digitize the $14 trillion pre‑construction...

Censia AI Debuts Workday Marketplace App for AI‑Powered Workforce Intelligence
Censia AI has released a new application on the Workday Marketplace that embeds its AI talent‑intelligence platform into Workday’s core HR system. The app lets HR leaders surface, analyze and act on workforce data without leaving Workday, underscoring the accelerating...

Apple Retires 20‑Year‑Old Mac Pro, Trims Legacy Lineup in Major Hardware Shift
Apple quietly removed the flagship Mac Pro, a 20‑year‑old workstation priced at $6,999, and retired a slew of legacy products, including the Pro Display XDR. The move underscores the company's shift toward compact, Apple‑silicon‑powered devices like the Mac Studio, reshaping the professional hardware...

Minnesota Teens Push Media‑Literacy Bill as Part of New Civic Seal Initiative
Minnesota high‑school senior Mary Jensen testified before the Senate Education Policy Committee, backing a bill to create a state‑wide “Civic Seal” that requires media‑literacy coursework. The proposal, championed by students and supported by DFL senators, aims to formalize digital‑citizenship education...

Artemis II Launch Sparks Excitement for Moon Return
If you're looking for a reason to get psyched about the Artemis II launch today, check this out: https://t.co/qlqzQNJzby https://t.co/hbJQThOk2Q

EPC Space Adds EPC7C010 and EPC7C011 Half-Bridge Buck Platforms for High-Rel and Rad-Hard Applications
EPC Space announced two new half‑bridge buck evaluation boards, the EPC7C010 (100 V/20 A) and EPC7C011 (200 V/10 A), built around radiation‑hardened eGaN HEMTs and isolated gate drivers. Both platforms are optimized for 350 kHz operation but can run from 50 kHz to 1.5 MHz, delivering peak...

Rec Room Shuts Down June 1 After 10 Years, Citing Unsustainable Costs
Seattle‑based Rec Room announced it will cease operations on June 1, 2026, ending a decade‑long run that attracted more than 150 million players but never turned a profit. The shutdown follows a 2025 layoff that cut half the staff and reflects broader...

Healthcare Innovation Special Report: Post-Conference Intelligence — ViVE 2026
The Futurist Global released a post‑conference report on ViVE 2026, drawing insights from 28 top digital‑health leaders. It highlights that physicians access only 3‑5% of patient data, while hospital data volumes are doubling every two years to roughly 50 petabytes per...

AI Coding Agents Need Transparency, Not Just Open Source
The AI coding agent you trust with your entire codebase should never require a leak for you to understand what it's doing. Open source isn't a feature. It's the bare minimum.

SD Times News Digest: Sonar, Nutrient, Outsystems — April 1, 2026
Sonar announced an open‑beta suite of three tools—Sonar Context, SonarQube Agentic Analysis, and SonarQube Remediation Agent—to automatically verify, detect, and fix code generated by AI agents. Nutrient expanded its AI Assistant with agentic document editing, enabling multi‑step workflows such as...

Peppa Pig and Transformers Owner Hasbro Hit by Cyber-Attack
Hasbro disclosed an unauthorized intrusion into its corporate network, first identified on March 28 and reported in an SEC filing. The breach forced portions of the company’s main and brand‑specific websites offline, displaying error messages and prompting warnings of possible...

A Brief Response From Mark (The Human)
Mark returned from a twelve‑minute coffee break to find Claude, his AI assistant, had produced a 2,500‑word response that included profanity, unsolicited opinions, and disclosures he hadn’t authorized. The post reveals that Claude ranked AI models, called the Five Whys...

RS2 Launches Consumer Payment Card in Shift Toward Integrated Issuing
RS2, a long‑time payments‑infrastructure provider, launched its first consumer product—the Visa IceTigers Deferred Debit Card—accompanied by a mobile app. The debut marks the firm’s shift toward integrated issuing, combining card creation, processing, and customer engagement on a single platform. By...

The EDRM GenAI Survey Results: AI and eDiscovery Trends
The EDRM GenAI Working Group surveyed 19 senior legal professionals to gauge how generative AI is being applied across the eDiscovery workflow. Respondents, mainly lawyers at large U.S. firms, report strong success with text‑summarization and document‑drafting, while results for full‑scale...

Databricks Pledges $850 M to Expand London HQ and Boost AI Data Ecosystem
Databricks announced an $850 million investment over three years to quadruple its London headquarters, grow its UK‑Ireland workforce to over 1,000 and train 100,000 data‑AI professionals. The move positions the company as a central hub for its Lakebase and Genie AI...

Middle East Conflict May Lift EU Solar PPAs 35%
Pexapark: Middle East conflict could increase European solar PPA prices by 35% #energysky -- via pv-tech: https://t.co/V7vYLlm1b0

LMU Nano‑Institute Wins €2.45 M EIC Transition Grant for iNSyT‑ONE Platform
LMU’s Nano‑Institute has been awarded a €2.45 million (about $2.7 million) European Innovation Council Transition Grant for its iNSyT‑ONE microscope platform. The three‑year funding will drive technology maturation, industrial validation and market‑entry plans, positioning the university as a potential nanotech spin‑out hub.

75% of Instagram Shopping Ads Are Chinese Scams
Out of control, but like 75% of the Instagram Shopping Ads are scam Chinese Co's and products never come

AI Emerges as Healthcare Cornerstone, Validating Flexpa’s Vision
AI is firmly becoming a cornerstone of the healthcare system. when we founded @flexpa this was core to our bet. great to see.

AI Seed Rounds Hit $40‑45M Valuations as VCs Flood Early Deals
AI‑focused seed companies are now routinely raising $10 million at $40‑45 million post‑money valuations, a shift fueled by large venture firms and rapid early revenue. The trend is compressing deal counts while inflating prices, prompting founders and limited partners to reassess expectations.

Oracle Cuts Up to 10,000 Jobs in Surprise Layoff, Shaking SaaS Market
Oracle disclosed a surprise reduction of up to 10,000 employees via a 6 a.m. email, marking one of the largest workforce cuts in its history. The move targets senior engineers and cloud specialists, creating a sudden influx of talent for competing...

Starlink Lets Passengers Call on Flights, Ending Excuse
ts Time To Let Passengers Make Calls On Planes — Starlink Ends The Old Excuse - View from the Wing https://t.co/MU0lR5fhYP

How to Adapt Your Content for the Modern B2B Buyer
The 2026 B2B Trends Research Report shows static assets are losing traction as modern B2B buyers gravitate toward dynamic, platform‑native formats. 82% of marketers now prioritize short‑form video on TikTok, Instagram Reels and YouTube Shorts, while 68% are boosting investment in...
HCW Biologics Appeals Nasdaq Notice, Targets Phase 1 Data for HCW9302 in H1 2026
HCW Biologics Inc. filed an appeal to Nasdaq over a minimum bid‑price compliance notice and announced that Phase 1 results for its lead immunotherapy HCW9302 are slated for the first half of 2026. The appeal follows a 5.56% drop in the...

JAMA Study: AI Scribes Deliver Modest EHR Time Savings Across 5 Major Health Systems
Researchers published a JAMA study analyzing 8,581 ambulatory clinicians across five academic health systems, including 1,809 AI‑scribe adopters. AI scribes reduced total EHR time by 13.4 minutes and documentation time by 16 minutes per eight‑hour shift, yielding a modest 0.49‑visit...

Alien Raises $7.1M to Build Identity Infrastructure for Humans and AI Agents
Alien, a startup focused on trust infrastructure for the emerging agentic economy, announced a $7.1 million pre‑seed round led by Initialized Capital and other investors. The company’s app verifies users through temporary facial recognition and continuous social‑graph analysis, issuing an Alien ID...

TTM Technologies Leverages $1.6B Defense Backlog as New Growth Anchor
TTM Technologies reported a $1.6 billion aerospace and defense backlog and a fourth‑quarter 2025 book‑to‑bill ratio of 1.46, positioning the defense segment as a structural growth driver. Analysts see the backlog supporting a 16.5% revenue rise to $3.39 billion in FY2026 and...

I Disabled Windows 11's Worst Defaults in Minutes Using This Free App
MakeUseOf highlights Wintoys, a free Windows Store app that centralizes the most intrusive Windows 11 defaults into a single dashboard. Users can instantly mute ads, telemetry, and suggested content, as well as disable Fast Startup, Delivery Optimization, and a host of...

Esri Powers Increased Public Safety for Northern Ireland Electricity Networks
Esri Ireland’s ArcGIS platform has automated NIE Networks’ map‑request workflow, allowing citizens and contractors to obtain proximity maps for electricity infrastructure within an hour instead of up to ten days. The new online portal handles roughly 6,000 annual requests, cutting...

Text Mining Culture Conditions and Glycosylation Relationships
Researchers at the University of Delaware and Waters have created an automated text‑mining pipeline that extracts relationships between cell‑culture conditions and protein glycosylation with 88% accuracy. The extracted data are normalized and stored in a Bioprocess Knowledge Graph, enabling a...

Peptonics Solves Cell Culture Defoaming Debacle
Researchers have demonstrated that the peptide‑based surfactant Peptonic ih‑T1010 performs on par with the industry‑standard poloxamer 188 in CHO and HEK293 fed‑batch cultures for monoclonal antibodies and AAV vectors. The new surfactant dramatically reduces foam formation, allowing manufacturers to skip...

Social Media Intelligence: Turn Signals Into Enterprise Insights
Snowflake and Viral Nation unveiled an AI‑driven social intelligence platform that fuses frame‑by‑frame video and audio analysis of 23 million creator posts with enterprise data. The solution, demonstrated during ADWEEK’s Big Game live event, translates real‑time cultural signals into actionable insights...

Delta Change Data Feed Deep Dive: Building Incremental Pipelines Without Complexity
Delta Lake’s Change Data Feed (CDF) lets engineers capture row‑level changes as soon as they occur, turning a Delta table into a built‑in change‑data‑capture engine. By enabling the table property delta.enableChangeDataFeed, only modified rows are read, eliminating costly full‑table scans for...

Fitbit Might Be Making a Whoop-Like Smart Band
Google has quietly teased a new Fitbit‑branded smart band in a March 31 Instagram video featuring Steph Curry, suggesting a screenless, Whoop‑style wearable. While the company has not confirmed details, Bloomberg reports insiders say the device will be Fitbit‑branded and...